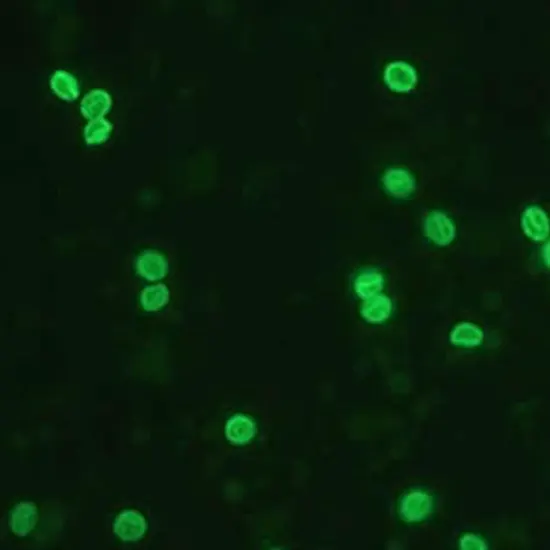

Cryptosporidium is a parasitic species that has become a growing concern for public health officers. This bitsy sponger can beget severe illness in humans, particularly those with weakened vulnerable systems.
Cryptosporidium is a parasitic species that has become a growing concern for public health officers. This bitsy sponger can beget severe illness in humans, particularly those with weakened vulnerable systems.
Cryptosporidium is transmitted through defiled water, food, and other objects, and can beget symptoms similar to diarrhea, stomach cramps, puking, and fever. In this blog post, we will explore what cryptosporidium is, how it spreads, and its impact on mortal health.
We'll also bandy the colorful measures that can be taken to help the spread of this dangerous sponger and cover stool routine yourself and your loved ones. However, read on, if you're interested in learning further about cryptosporidium and how to stay healthy and safe.
1. Preface to Cryptosporidium?
Cryptosporidium is a protozoan sponge that infects the bowel of humans and creatures, causing a complaint called cryptosporidiosis. The sponge is set up in the feces of infected individualities and creatures, and is transmitted through defiled water, food, or shells. Cryptosporidiosis is a major concern for public health, especially in developing countries where access to clean water and sanitation is limited.
The complaint can beget severe diarrhea, dehumidification, and weight loss, and can be life- hanging in immunocompromised individuals similar as those with HIV/ AIDS or witnessing chemotherapy.
The sponger is resistant to chlorine and other detergents generally used in water treatment, making it a challenge to control its spread. In recent times, there have been several outbreaks of cryptosporidiosis stool culture linked to polluted water sources, pressing the need for bettered forestallment and control measures.
Understanding the biology and transmission of Cryptosporidium is critical for developing effective strategies to help and treat cryptosporidiosis. In this composition, we will explore the lifecycle of the sponger, its impact on mortal health, and the current sweats to control its spread.
2. Symptoms of Cryptosporidiosis?
One of the most concerning aspects of Cryptosporidiosis is its symptoms. The sponger can beget a range of symptoms, and in some cases, it can be life- hanging, especially in individuals with weakened vulnerable systems. The symptoms of Cryptosporidiosis generally develop within two to ten days after exposure to the sponger.
These symptoms can last for over two weeks or further, indeed in people with healthy vulnerable systems. The most common symptoms of Cryptosporidiosis include severe diarrhea, abdominal cramps, nausea, puking, and fever. Diarrhea can range from mild to severe, and in some cases, it can be watery and gushing.
This can lead to dehumidification, which is a serious concern, especially in children and the elderly. In some cases, Cryptosporidiosis can be accompanied by other symptoms, similar as loss of appetite, serum electrolytes weight loss, and fatigue. In individualities with weakened vulnerable systems, Cryptosporidiosis can beget more severe symptoms, including patient diarrhea, severe dehumidification, and indeed death.
It's important to note that the symptoms of Cryptosporidiosis can be analogous to those of other gastrointestinal infections. However, it's essential to seek medical attention incontinently, If you witness any of these symptoms. Your healthcare provider can perform individual tests to confirm the opinion and recommend the applicable treatment to palliate the symptoms and help complications.
3. Causes and transmission of Cryptosporidiosis?
Cryptosporidiosis is caused by the presence of the Cryptosporidium sponger in the body. This sponge is generally set up in the fecal matter of infected humans or creatures. The transmission of this sponger can do through several routes. The most common route of transmission is through the ingestion of polluted water. Other possible routes of transmission include person- to- person contact, consumption of defiled food, and contact with defiled shells.
Cryptosporidium has a hard external shell that allows it to survive for extended ages outside of its host. This means that it can survive in water or on shells for days or indeed weeks. This makes it veritably delicate to help the spread of this sponger, especially in places where the hygiene norms aren't maintained.
In areas where the water quality isn't well- regulated, similar to developing countries or pastoral areas, the threat of transmission is significantly advanced. In addition, individuals with weakened vulnerable systems, similar as those with HIV/ AIDS, cancer, or witnessing chemotherapy, are at an advanced threat of developing severe and long- continuing symptoms of cryptosporidiosis.
To help the transmission of Cryptosporidium, it's important to exercise good hygiene, especially when handling food or water. Washing hands completely with cleaner and water before and after reflections, cect whole abdomen and after using the restroom is a simple yet effective way to reduce the threat of infection. Boiling water, using water pollutants or cleansers, and avoiding ingestion of polluted water sources can also help the transmission of this sponger.
4. Opinion and treatment of Cryptosporidiosis?
Opinion and treatment of Cryptosporidiosis is pivotal in managing the complaint and precluding it from getting severe. The opinion of Cryptosporidiosis can be grueling because the symptoms are analogous to those of other gastrointestinal ails.
A croaker may request a coprolite sample to test for the presence of the sponger in the coprolite. The sample is also examined under a microscope to identify the sponger’s presence. Presently, there's no specific treatment for Cryptosporidiosis. Still, some medicines can palliate the symptoms and the infection generally goes down by own within two weeks in else healthy individuals.
Treatment is substantially concentrated on managing the symptoms, similar to dehumidification and diarrhea, which can lead to severe complications if left undressed. For people with weakened vulnerable systems, similar as those with HIV/ AIDS or individualities witnessing chemotherapy, the illness can be severe and long- continuing and hospitalization may be necessary.
In similar cases, antimicrobial remedy may be specified in combination with other probative treatments, similar as rehydration remedy, to manage the symptoms effectively. Prevention of Cryptosporidiosis is crucial in controlling the spread of the sponger.
Proper hygiene practices, similar as washing hands completely with cleaner and water, avoiding contact with polluted water or shells, and rehearsing safe food medication styles can help prevent infection. Also, water treatment and filtration systems can help reduce the threat of waterborne transmission of the sponger.
5. Prevention and control measures for Cryptosporidiosis?
Prevention and control of Cryptosporidiosis is important to reduce the threat of infection and the spread of the sponger. The following measures can be taken to help Cryptosporidiosis:
Water Treatment
Cryptosporidium can be set up in undressed water sources, so it's important to use a water treatment system that's able to remove or kill the sponge. External water treatment systems are needed to meet certain norms, but if you have a private well, you should have your water tested regularly.
Hand washing
Proper hand washing is essential to reduce the threat of infection. Hands should be washed with cleaner and warm water for at least 20 seconds before and after preparing food, after using the restroom, changing a diaper, or handling creatures.
Avoid Contamination
It's important to avoid impurity of food and water sources. This includes washing fruits and vegetables completely, cooking meat to the recommended temperature, and not swimming in public pools if you have diarrhea.
Personal Hygiene
It's important to maintain good hygiene, including keeping your nails trimmed, avoiding touching your face, and washing your hands regularly.
Insulation
If you have Cryptosporidiosis, it's important to avoid contact with others to help the spread of the sponger. This includes staying home from work or academy until symptoms have resolved. By taking these measures, the threat of Cryptosporidiosis infection can be reduced, and the spread of the sponger can be controlled.
6. Challenges in controlling Cryptosporidium outbreaks?
Cryptosporidium outbreaks are particularly challenging to control. One reason for this is because the Cryptosporidium sponger can survive in the terrain for long ages of time. This means that indeed if an infected person is no longer in the area, others can still come infected through contact with polluted water or food sources.
In addition, the sponger is resistant to numerous common detergents, making it especially delicate to exclude from water inventories.
Another challenge is that people infected with Cryptosporidium can continue to excrete the sponger in their feces serum urea for several weeks after symptoms have subsided. This means that infected individualities may intentionally spread the sponger to others, indeed if they feel fine.
Also, there’s presently no effective vaccine or treatment for Cryptosporidium infection. While some specifics can help to relieve symptoms, they don't actually cure the infection. This means that forestallment is crucial when it comes to controlling outbreaks.
One of the most important ways in precluding Cryptosporidium outbreaks is to insure that water sources are duly treated and maintained. This includes both drinking water and recreational water sources, similar as swimming pools and water premises.
It's also important for individualities to exercise good hygiene, similar as washing hands completely and constantly, particularly after using the restroom, changing diapers, or handling creatures. Overall, Cryptosporidium outbreaks can be delicate to control, but with proper forestallment measures and prompt action when outbreaks do, it's possible to minimize their impact on mortal health.
We hope that you set up our blog post instructional and perceptive in respects to cryptosporidium and its impact on mortal health. As you can see, this parasitic species can be particularly dangerous for certain populations, including children and individualities with weakened vulnerable systems.
It's important to take proper preventives to help the spread of cryptosporidium, similar as rehearsing good hygiene and avoiding polluted water sources. We hope that this blog post has helped you understand further about this parasitic species and its impact on mortal health. Stay healthy, stay informed!









